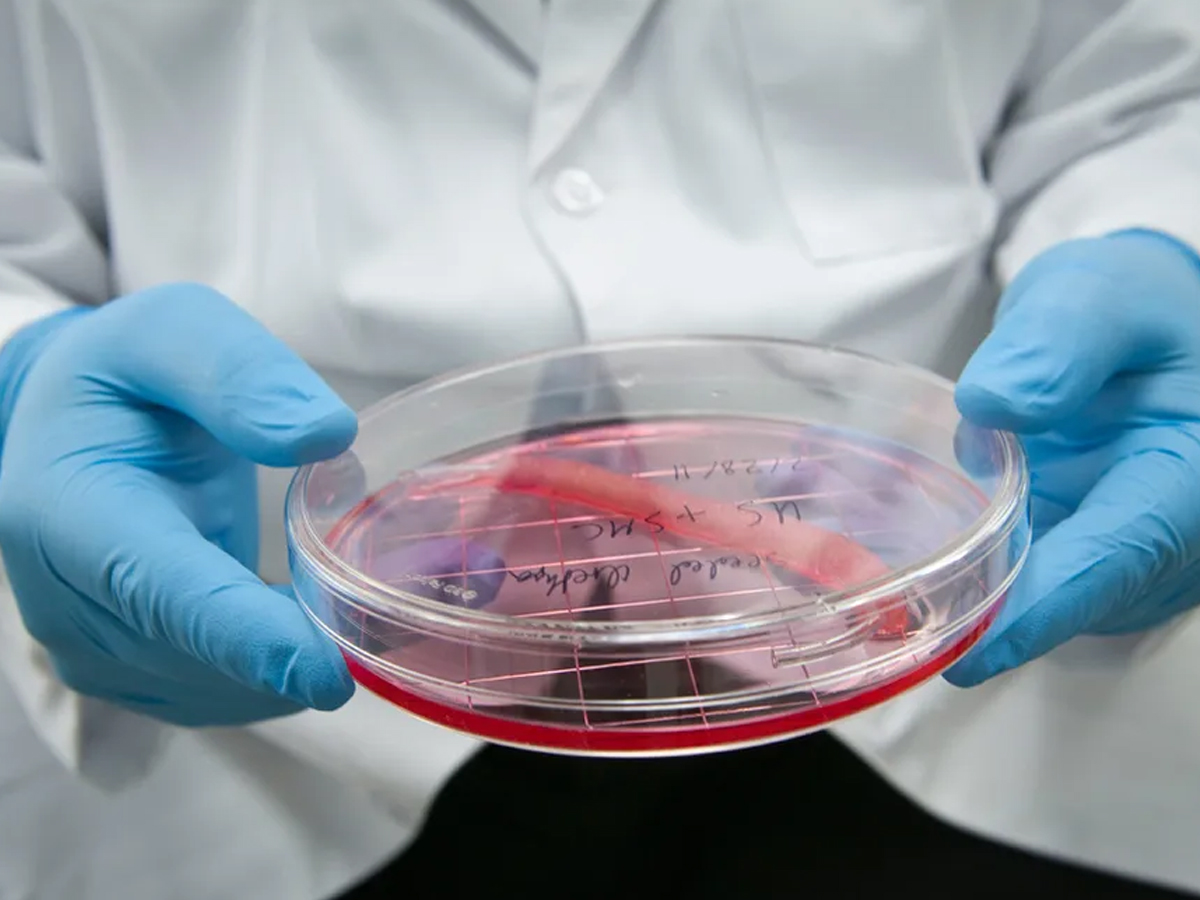
Baba Vanga 2025 Predictions: Earthquakes, Wars & Alien Encounters That Came True - Gallery Image

Baba Vanga 2025 Predictions: Earthquakes, Wars & Alien Encounters That Came True
The world has been captivated by the enigmatic predictions of the blind Bulgarian mystic Baba Vanga. Many of her prophecies have been connected to world events over the years, including political upheavals and natural disasters. Many of her predictions, including catastrophic earthquakes, volcano eruptions, and economic instability, have already materialized in 2025.
These are some of the most discussed Baba Vanga predictions for 2025 that continue to pique interest and provoke discussion throughout the globe.

Who is Baba Vanga?
The visionary herself, whose cryptic prophecies continue to fascinate the world.

Earthquakes of 2025 – Myanmar
A 7.9-magnitude quake devastated Myanmar in March 2025, fulfilling Vanga's “shattering earthquakes” prophecy. (Photo: NDRF)

Earthquakes of 2025 – Russia
The 8.8-magnitude quake in Russia’s Kamchatka in July triggered tsunami alerts—a second major earthquake in line with her vision. (Photo: Reuters/Administration of the Governor of Kamchatka Krai)

Volcanic Eruptions After Quake
The powerful Russian quake awakened at least seven volcanoes—echoing Vanga’s “double fire from earth and sky” prediction. (Photo: X/YassSmith)

Economic Instability Predicted
Vanga foresaw global economic collapse in 2025, a vision now linked to US tariffs and destabilised markets. (Graphic: Freepik)

War in Europe 2025
A catastrophic European war is predicted by Vanga, potentially ignited by geopolitical tensions in 2025. (Photo: Evgeniy Maloletka/AP)

Europe Splitting Apart
Vanga envisioned Europe fracturing—perhaps through political or territorial breakdown—in the year 2025. (Illustration: Michael Vogtmann)

Alien Appearance at Sports Event
Vanga predicted live alien contact during a major athletic event in 2025—blurring lines between prophecy and spectacle. (Photo: Mark J. Rebilas/US Presswire)
Lab-Grown Organs Breakthrough
Vanga envisioned 2025 as the year organs like hearts and kidneys could be grown in labs—paving the way for a medical revolution. (Photo: Wake Forest School of Medicine)






